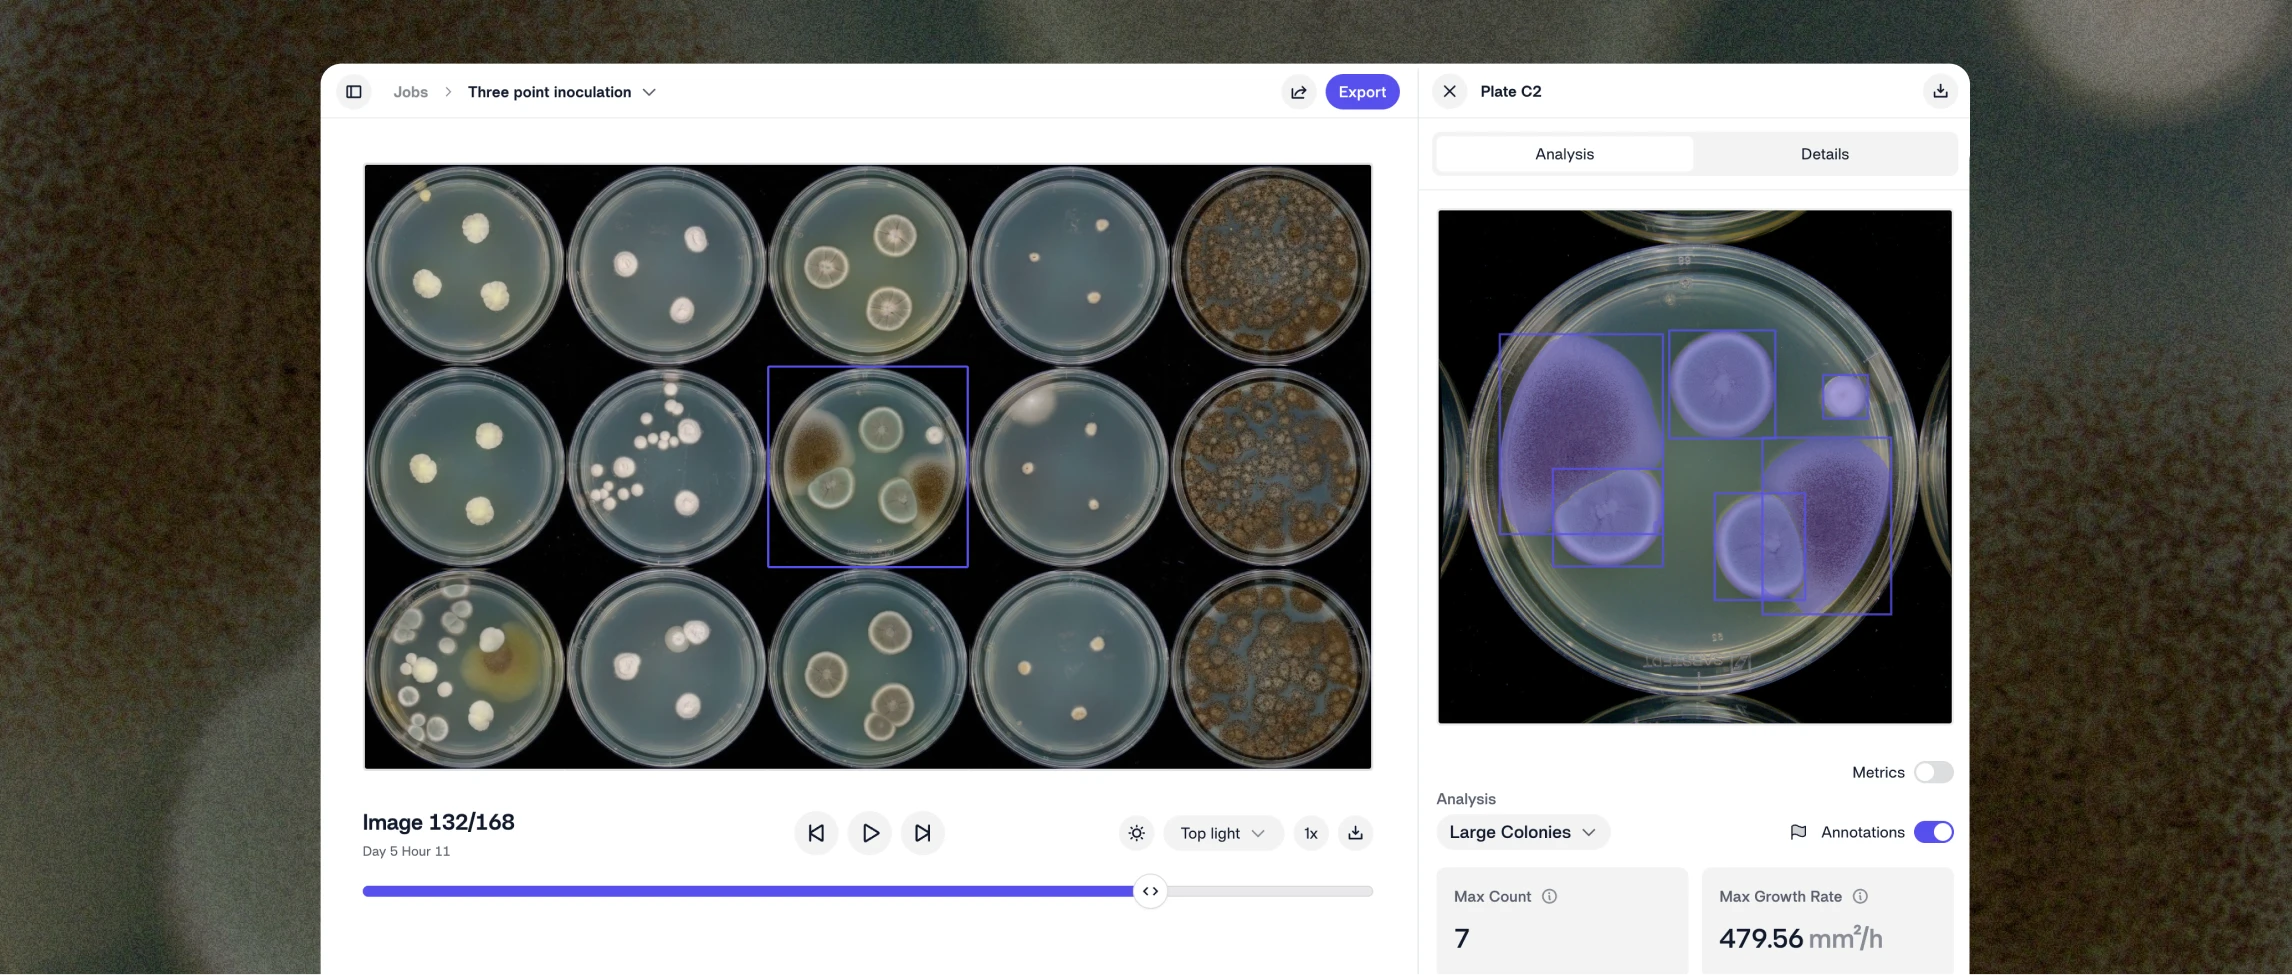
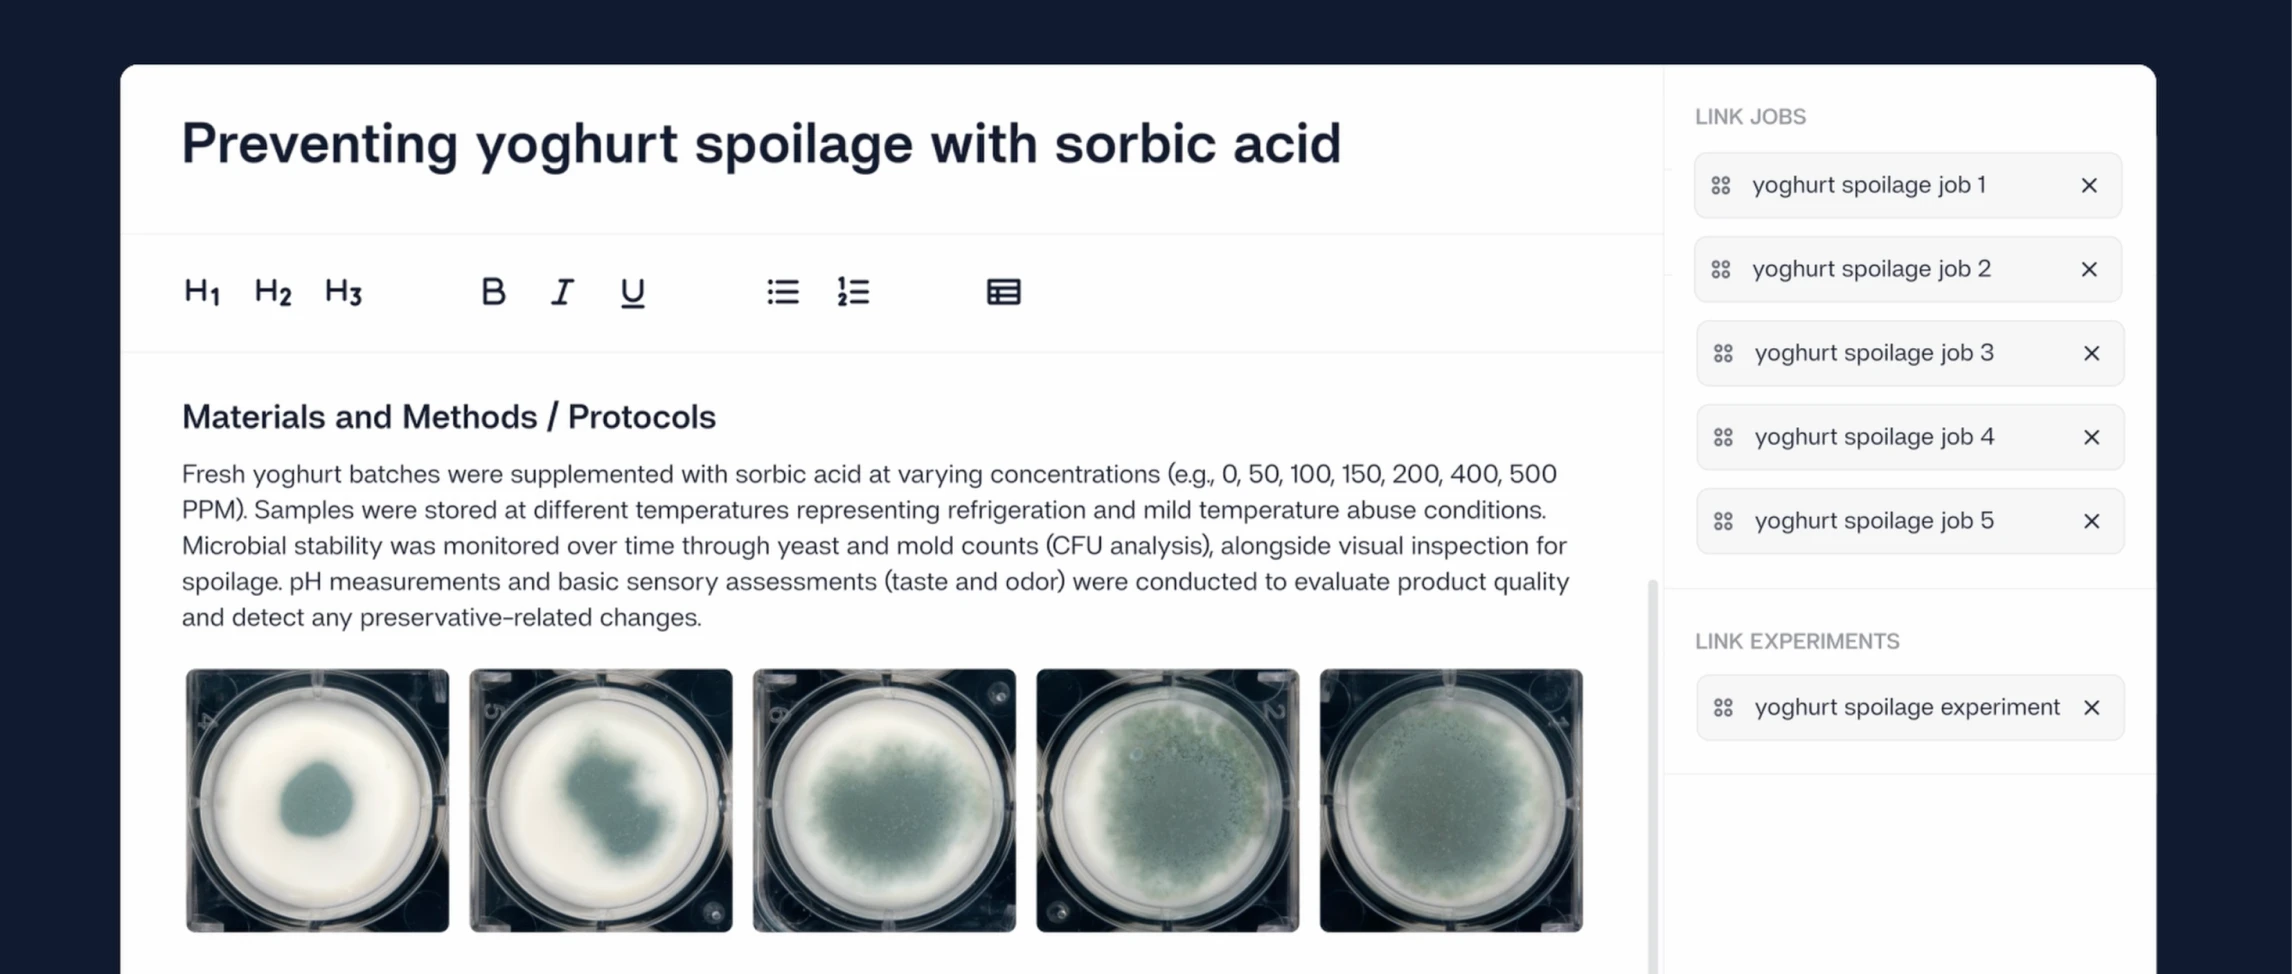

“With the help of Reshape, we have moved further in improving the workflow in 6 months than in the 3 years before with other solutions we tried.”
“Getting deep insights into everything that happens during our experiment is hugely helpful to discover new phenomena more quickly.”
"The Reshape system has revolutionized how we screen and study microbial clones. We can now track metabolite production, release, and diffusion at an unprecedented scale.”
Prepare experiments with clarity. Track every plate with context.
Structure experimental intent before work begins so every well and parameter remains connected from preparation through analysis to final conclusion.

Translate intent to setup
Capture experimental parameters and context at the start, and see the platform transform into plate layouts and run conditions.

Reduce preparation errors
Use plate maps and visual guidance to prevent mistakes during your setup.

Structure context for rich downstream insights
When plate maps are connected to captured results, you instantly reveal performance across a wide range of conditions.



Capture experiments as they unfold
Automate imaging to dramatically increase time resolution without manual work. Watch discovery happen in real time and build out a structured data foundation that teams can understand in context across experiments, teams, and time.




Run experiments 24/7
Smart Incubators automate imaging and run around the clock, allowing experiments to run overnight and over weekends without losing a single data point.
Document every well
Link high-resolution images to every analysis result so scientists can review outcomes in context and verify results instantly.

Reliable data capture
Maintain stable conditions with built-in incubation and multiple light modes that can capture images across a wide range of media and organisms.
AI models that turn every assay into objective, digital data
AI-powered analysis, trained on large-scale biological datasets, converts captured images into accurate, standardized data points. Reshape supports a wide range of assays, including growth kinetics, total viable counts, morphology, and many more.
Total viable count
Quantify microbial load by counting colony-forming units.


Differential counts
Count colony-forming units for different types of cells and colonies (based on morphology, color, or size).


Growth kinetics
Track microbial growth dynamics over time.


Insects health
Measure insect life-stage parameters like hatchability, growth rates, pupation, eclosion, and mortality.


Fluorescence
Detect and quantify recombinant GFP/RFP strains and their expression levels.
.png)
.png)
Colorimetric
Monitor pH, metabolic activity, or growth via color change.


Turn every captured well into a reusable scientific asset
Reshape automatically captures and structures experimental data in a secure system, making experiments searchable, shareable, and audit-ready while creating global visibility across teams and labs.

Capture automatically and find instantly
Images, data, and insights are automatically recorded, are searchable, and can be exported with one click.


Secure collaboration across labs
Centralized cloud access lets teams share experiments across sites while maintaining compliance.

All data captured or entered in Reshape can be exported to LIMS and other systems, or synced automatically via API.

















Build a structured foundation for every experiment
Stop stitching together spreadsheets and results from disconnected tools. Automate the routine, eliminate manual handoffs, and unlock new experimental insights automated across all your labs.